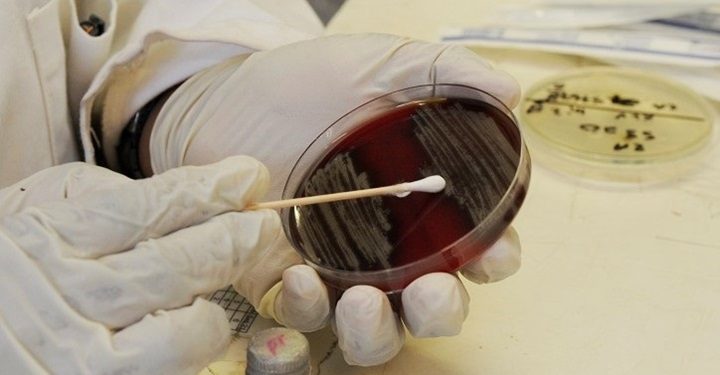
decesso

Salgono a quattro i decessi di persone in Campania che hanno contratto il Coronavirus. Le cause non sarebbero direttamente attribuibili al Covid-19, ma ad altre patologie di cui i malati già soffrivano in precedenza. L’ultimo dei decessi di persone che avevano contratto il Coronavirus riguarda una 47enne di Napoli, Teresa F. La donna soffriva già di una grave patologia, una forma di epilessia, che ha influito sulla dipartita della donna. Il suo decesso era diventato un polverone mediatico a causa di un video fatto dal fratello, Luca, in cui si denunciava un presunto ritardo nella comunicazione dell’esito del test. “Le istituzioni ci hanno abbandonato” dice nel video Luca, che ha denunciato la negligenza delle autorità competenti. Il ritardo ha creato un enorme disagio alla famiglia, già sconvolta per il decesso della 47enne, e la salma della donna è rimasta bloccata in casa per oltre 24 ore. Nell’appartamento in piazza Carlo III erano presenti, oltre al fratello Luca, anche i genitori della donna, un’altra sorella con il marito e i due figli. Tutti e sette i familiari sono stati posti in quarantena.
Il terzo dei quattro decessi registrati fino ad ora, invece, riguardava una donna di 84 anni, di Ottaviano, morta ieri all’ospedale di Nola. È molto probabile che l’anziana signora abbia contratto il virus da suo figlio, rientrato nei giorni scorsi da Milano. La signora e la sua famiglia non avevano comunicato questo importantissimo dettaglio e, siccome non erano presenti sintomi che facessero pensare al Covid-19, la donna è stata trattata per un’edema polmonare, una patologia acuta cardio-respiratoria. Quando è trapelata la notizia, si è proceduto immediatamente a porre in isolamento 21 persone, tra infermieri, operatori sanitari e medici. Di conseguenza è stato predisposto un arruolamento di personale da altre strutture. I reparti dell’ospedale di Nola nei quali è transitata la signora sono stati prontamente chiusi e sottoposti a sanificazione. Si sta procedendo, intanto, per avviare le procedure di sicurezza previste, come l’isolamento per l’edificio della famiglia della vittima e quello adiacente.